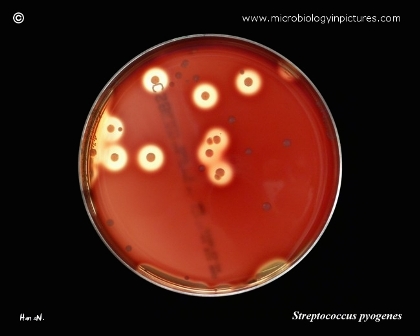

ỐNG NGHIỆM
- 1. ỐNG NGHIỆM LẤY MÁU CÁC HÃNG
- 3. TEST NHANH SÀNG LỌC
- 4. ĐỒ PHÒNG HỘ-BẢO HỘ
- 4. LỌ NHỰA CHAI NHỰA
- 5.VẬT TƯ XÉT NGHIỆM
- 7. SPA VẬT TƯ Y TẾ
- 8. ỐNG NGHIỆM BD USA
- 9. THIẾT BỊ Y TẾ
- 10. DỤNG CỤ ĐỰNG RÁC Y TẾ
- 11. GIA CÔNG ÉP NHỰA
- 12. DỤNG CỤ INOX-Y TẾ
- 14. VẬT TƯ Y TẾ
- 15. VẬT TƯ PAP - GPB
- 16. DỤNG CỤ PHÒNG THÍ NGHIỆM
- 18. ỐNG NGHIỆM NHỰA
- 20. ĐÁ GEL TRỮ LẠNH
- 21. VẬT TƯ PHÒNG THÍ NGHIỆM
- 22. DỤNG CỤ VỆ SINH PHÒNG THÍ NGHIỆM
- 23. TEST XÉT NGHIỆM
- 24. Họ nhuộm vi sinh- Tế bào
- 25. VẬT TƯ PRP
- 26. SẢN PHẨM GIA DỤNG
- 27. KIẾN THỨC Y HỌC
- 28. VIỆC LÀM XÉT NGHIỆM
- 29 KỸ THUẬT XÉT NGHIỆM
- 21 DỤNG CỤ THỦY TINH PYREX - MỸ
- 31. KHẨU TRANG Y TẾ
- 32 DANH SÁCH TỔNG HỢP
- 33 DỤNG CỤ Y TẾ GIA ĐÌNH
tiện ích
Chi tiết sản phẩm
Thông tin chi tiết
Xét nghiệm antistreptolysin O (ASO) trong máu. ASO là một kháng thể trong máu giúp chống lại kháng nguyên là độc tố streptolysin O, là độc tố do vi khuẩn liên cầu nhóm A tiết ra bền nhiệt vi vậy khi vi khuẩn tấn công vào thực phẩm hay cơ thể thì độc tố vẫn còn tác dụng gây ngộ độc . ASO và anti DNase B là các kháng thể phổ biến nhất được sản xuất bởi hệ thống miễn dịch của cơ thể khi bị nhiễm liên cầu khuẩn nhóm A.
Liên cầu khuẩn nhóm A (Streptococcus pyogenes)

Là vi khuẩn gây viêm họng . Trong hầu hết trường hợp, nhiễm trùng strep được xác định, được điều trị bằng thuốc kháng sinh, thì hầu hết giải quyết tốt các bệnh nhiễm trùng. Khi bị nhiễm trùng strep không gây ra các triệu chứng , không biết nguyên nhân, nên không được điều trị hoặc điều trị không hiệu quả thì một số (rất hiếm) người, đặc biệt ở trẻ nhỏ có thể phát triển các biến chứng sau nhiễm liên cầu như: sốt thấp khớp, viêm cầu thận có thể gân thấp tim. Những biến chứng này ít phổ biến ở Mỹ vì thử nghiệm ASO thường xuyên được chỉ định, nhưng vẫn còn xảy raở Mỹ. Chúng gây ra các triệu chứng như sốt, mệt mỏi , tim đánh trống ngực, khó thở , giảm lượng nước tiểu, nước tiểu có máu. Bệnh có thể làm gây rối loạn chức năng thận cấp tính, sưng chân (phù nề), và tăng huyết áp. Các triệu chứng này cũng có thể do nguyên nhân khác, vì vậy xét nghiệm ASO giúp xác định nguyên nhân nếu gần đây bệnh nhân bị nhiễm trùng do Streptococcus Spp
copy
Sản phẩm cùng loại
HƯỚNG DẪN SỬ DỤNG BỘ NHUỘM PAP’ SMEAR
Giá: 2,300,000 VNĐChi tiết
DUNG DỊCH LISS
Giá: Liên hệChi tiết
Dung dịch đệm Phosphat saline 7.2
Giá: 90,000 VNĐChi tiết
dung dịch thí nghiệm Hóa chất KOH 20%
Giá: Liên hệChi tiết
Think prep Pap
Giá: Liên hệChi tiết


Địa điểm kinh doanh: 7/95 Hẻm Cư Xá Đồng Tiến -Thành Thái Phường 14, Quận 10, TP.HCM
Hotline: 0903685363 - 028 66821363
congtykhaivan@gmail.com
http://ongnghiemkv.com/
Đang online: 31